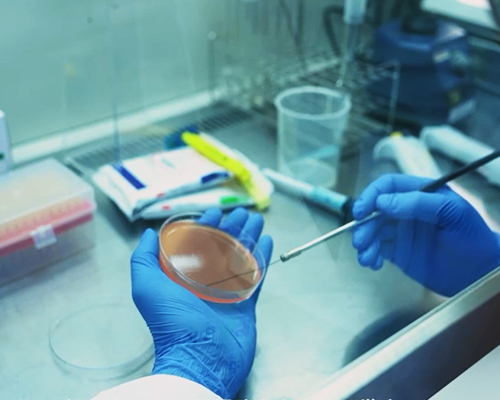

Business Information
Our Strength
Professional research and development capabilities.
Our own office building has sufficient storage and inventor.
Strict quality inspection, food safety assurance.
Having our own research and development team.
Automated aseptic production workshop.

Customer-oriented
We pursue the fundamental value of ‘customer satisfaction’ through
continuousinvestment and innovation of product R&D.
We are constantly striving to develop the best products
for health and taste based on customer feedback
Trust Management
We employ necessary professionals
in each field and operate structured systems
such as the latest production facilities and fast and
accurate logistics networks.
Global Business
We are also forerunning in the global markets in overseas such as Mongolia, Vietnam, Malaysia, Indonesia, Japan, UK, Thailand, Singapore, etc.
Food Manufacturing/OEM
We provide customized consulting to develop and manufacture menus that customers want and continue to deal with customers in various fields, including professional franchise companies, with our own competitive manufacturing technology that has evolved for 13 years.



